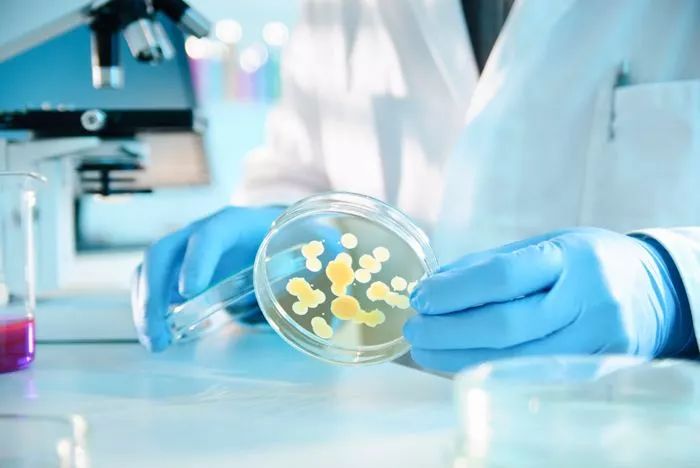
国内抗生素形势分析,全球医药研发现状趋势

作者: 向飞
美国The Medicines Company(下文简称MDCO)于当地时间2017年11月29日发布公告,宣布将其抗菌药业务转让给Melinta公司,而后者将为此向MDCO一次性支付2.7亿美元的首期款与保证金,且在将来根据不同的销售情况支付5~25%的销售提成。虽然MDCO在其公告中宣称,转让出抗菌业务是为了让公司将各种资源集中于抗脂药物inclisiran的开发,而且也获得了公司董事会成员的一致同意,但结果仍然让笔者略感惊讶,因为此次转让给Melinta的抗菌药业务不仅包括了MDCO上市已久的Oritavancin Diphosphate(商品名:Orbactiv,2014年8月获FDA批准)与米诺环素(商品名:Minocin,2013年12月收购Rempex而得),还包括了该公司2017年8月29日新获FDA批准的美罗培南/Vaborbactam复方(商品名:Vabomere),其中Orbactiv与Vabomere均获得了FDA授予的QIDP资格(即:合格感染疾病产品),并均通过优先审查而获得批准,两者的临床优势不言而喻。
问题一:MDCO为何要转让其抗生素业务
Clinicaltrials.gov共登记了MDCO承办的12项与Oritavancin相关的临床试验(包括2项样本量为1000多例且已完成的大规模Ⅲ期临床试验)以及4项与Vaborbactam相关的临床试验(包括2项样本量为550例且已完成的Ⅲ期临床试验),估算其研发费用远超2.7亿美元。另据MDCO各年度的10-K报表,2009年~2013年间,Oritavance的研发费用达1.33亿美元;此外,根据其2014年10-K报表,该公司收购Rempex的米诺环素与美罗培南/Vaborbactam时,向Rempex支付了1.40亿美元的首期款。因此,此次转让抗生素业务对于MDCO而言,无疑是一次亏本的交易。So why?
1. 专注于inclisran的开发
Inclisiran(原名PCSK9si或ALN-PCSsc)是由MDCO与Alnylam Pharmaceuticals于2013年10月达成协议,合作开发的以PCSK9为靶点的GalNac偶合的RNAi疗法,临床拟用于治疗高胆固醇血症。与其他结合血流内PCSK9的抗PCSK9单克隆抗体相比,inclisiran是首个通过阻断肝脏内PCSK9合成而发挥作用的药物。
2017年8月29日,MDCO与Alnylam联合公布了inclisiran一项Ⅱ期临床试验(ORION-1)的结果显示,inclisiran能强效地降低LDL-C(第150天时,平均降低56%,最高降低81%),而且作用效果持久(51%的受试者的降LDL-C作用可维持6个月),且少有个体差异性。就其安全性而言,inclisiran的不良反应事件与安慰剂相似,未见实质性的安全性问题。该项试验为Ⅲ期临床试验中所用剂量的选择提供了依据,而Ⅲ期临床试验也于2017年11月6日正式启动。2017年11月,FDA对inclisiran授予了突破性疗法的资格。
MDCO在公告中指出,全球范围内约有1亿人采用以他汀类为主的降脂药物降低LDL-C与相关的死亡风险、非致死性心肌梗死与非致死性卒中或相关的事件。但是仍然无法完全消除心血管事件的风险,而且他汀类药物也有诸多人所共知的不中。首先,并非所有患者的LDL-C能达到足以预防临床事件的水平;其次,并非所有患者都耐受他汀类药物;最后,观察性研究显示,50%以上的患者对6个月以上的他汀类药物治疗无依从性。
目前,他汀类药物的专利期均已届满,仿制药纷纷上市,因此销售额均有大幅下降,然而根据美国处方药信息网(www.rxlist.com)提供的信息,瑞舒伐他汀钙(商品名Crestor)、依折麦布/辛伐他汀复方(商品名Vytorin)与阿托伐他汀钙(商品名Liptor)在月处方量Top 100的榜单中分别位列第2、49与93名。
正因为inclisiran具有的潜在的临床与市场价值,MDCO的股东才一致同意此次转让,从而能将更多的资源集中用于inclisiran的开发。
2 抗生素业务并未给MDCO带来预期的收益
根据MDCO的季度财务报告,2015年至今Orbactiv与Minocin的季度销售额如下图所示。

2009年,MDCO收购了Targanta,从而获得了oritavancin的开发与销售权,并于2014年8月获FDA批准,商品名Orbactiv。虽然2017年第3季度Orbactiv销售额较2015年第1季度增长了4倍多,但仍未突破千万元大关,而且本季度Orbactiv的直接研发费用高达630万美元,再加上销售与其他成本,Orbactiv对公司带来的利润微乎其微。另一种抗生素Minocin的销售额也不尽如人意,2015年至今的总销售额仅为2140万元。2013年12月,MDCO收购Rempex时支付了1.40亿的首期款,Vabomere获FDA批准时又支付了2.14亿美元的里程碑付款,而2017年前三季度,Vabomere的研发费用高达2407万美元。面对该公司惨淡的抗生素业绩,将来是否能收回研发与收购成本,是一个很大的未知数。
除了抗菌药业务板块不尽如人意,MDCO的整体营业情况也面临着严峻的考验。由于该公司的主打产品Angiomax(比伐卢定)专利期届满,MDCO不得不采取降价措施以应对越来越多的仿制药竞争。此举导致该公司2017年前3季度的产品营业收入较2016年同期降低了52.7%,仅为3814万美元。随着insclisiran进入Ⅲ期临床试验,MDCO用其表现欠佳的抗菌药业务换来资金,用于支持inclisiran的临床试验以及后续的行政申报,无疑是一个丢卒保车的抉择。
正是由于转让抗菌药业务对MDCO的潜在利好,该公司的股价在其宣布转让决定当天开盘前即上涨了5.3%。问题二、Melinta公司为何愿意收购MDCO的抗生素业务
1. Melinta公司自身的产品结构
Melinta公司,原名Rib-X公司,是一家专门从事抗菌药物研发的创新型制药企业。2017年6月,FDA批准Melinta公司研发的氟喹诺酮类抗菌药Delafloxacin(商品名Baxdela)用于治疗ABSSSI。此外,该公司的研发管线中多种抗菌药还在针对多种感染性疾病进行临床开发(表1)。因此,收购MDCO的抗菌药业务将有助于巩固Melinta公司在全球抗菌药市场中的地位。

图1 Melinta公司的主页截图
表1 Melinta公司的研发管线


2. 对新型抗菌药的医疗需求
Orbactiv获得FDA批准的适应证是用于治疗急性细菌性皮肤与皮肤组织感染(ABSSSI)
MDCO在其2014年10-K报表中指出,虽然多种其他抗菌药物可用于治疗ABSSSI,但这些抗菌药物却存在有很多重大缺陷,包括:
细菌的多药耐药性现象日趋严重
部分抗菌药属于抑菌剂,主要抑制病原菌的生长,而其对病原菌的杀灭作用则很大程度上依赖于机体的免疫系统。相比之下,包括Orbactiv与Vabomere在内的杀菌剂,则可不依赖于免疫系统地杀灭病原菌。
许多用于ABSSSI治疗的药物在其给药的顺应性上存在诸多不足,因其静脉给药次数通常会多于一次,而在某些情况下需要连续用药七天或七天以上,并且每天需要注射1或2次,并且可能需要借助于导管。
大多数静脉注射的抗生素用于治疗MRSA所致的ABSSSI时,需要对患者进行密切的血液监测
3. 与Vabomere自身的优势
MDCO指出,Orbactiv对敏感菌有着浓度依赖性的杀灭作用,而且γ相半衰期长达245小时,从而使该药成为首个也是唯一获FDA批准单次给药用于治疗ABSSSI的药物。两项大规模Ⅲ期临床试验(SOLO-Ⅰ/Ⅱ)均证实单剂量的Orbactiv对ABSSSI的治疗效果非劣于连续给药7天的万古霉素。
虽然MDCO未具体描述Vabomere的优势,但是该药对于多药耐药性细菌也有较好的抗菌作用,而且是首个上市用于治疗多药耐药性细菌感染的培南类与β-内酰胺酶*制剂抑**的复方,其中的美罗培南是培南类药物的市场领导者。此外,FDA对Orbactiv与Vabomere授予的QIDP与优先审查,也是对两种药物临床优势的充分体现。
4. 独占权
(1)Orbactiv
虽然MDCO从Targanta收购的Orbactiv基础专利在美国的有效期于2016年届满,但该公司却向USPTO申请将基础专利的有效期延续至2020年11月,目前暂时批准的专利期于2017年11月届满(US5840684与US 5998581)。此外,保护Orbactiv治疗特定皮肤感染的用途专利有效期截至2029年8月(US8420592),另有两件组分专利分别于2030年4月(US9682061)与2035年7月(US9649352)届满。
除了专利,Orbactiv根据GAIN法案与NCE法案所享有的独占权分别截至2024年8月与2019年8月。
(2)Vabomere
根据Orange Book的数据,Vabomere中Vaborbactam的基础专利(US8680136)将于2031年届满,暂未披露独占权信息。问题三、FDA与/或EMA近年来还批准了哪些抗菌药?其市场表现怎么样?
FDA与/或EMA近年来批准的抗菌药如下表所示。
表2 2010年以来FDA与/或EMA批准的抗菌药


1. Ceftaroline Fosamil
Ceftaroline Fosamil是最先由武田制药开发的一种前药型头孢菌素类抗生素,其不仅对包括MRSA在内的革兰阳性菌有较强的抗菌活性,还具有广谱的抗革兰阴性菌活性,并保留了头孢菌素良好的安全性特征。2005年,武田制药将日本以外地区的Ceftaroline Fosamil的开发与销售权独家转让给了Cerexa,后者于2006年被Forest Laboratories收购(4.8亿美元)。2009年,Forest与阿斯利康达成协议,在美国与加拿大以外的其他国家/地区共同开发Ceftaroline Fosamil。2011年,武田制药将日本国内Ceftaroline Fosamil的开发权与销售权转让给住友制药。2016年,阿斯利康又将抗感染业务出售给了辉瑞公司。
Actavis在2014年7月收购Forest(250亿美元)后又于2015年7月收购Allergan,并将自身的名称改为Allergan。
注:2016年8月,阿斯利康将其小分子抗生素业务出售给辉瑞,而辉瑞为此支付了5.50亿美元的首付款,且将支付4.25亿美元的里程碑付款以及6.00亿美元的销售相关性付款。此次交易覆盖了已经上市的美罗培南(商品名:Merrem)、Ceftaroline Fosamil(商品名:Zinforo)与头孢他啶/Avibactam(商品名:Zavicefta)以及尚处于临床试验阶段的ATM-AVI与CXL。
2. Dalbavancin
Dalbavancin是一种半合成的脂糖肽类抗生素,可与初生细胞壁肽聚糖干五肽的D-丙氨酰-D-丙氨酸末端结合,从而干扰细胞壁合成。Dalbavancin最早Vicuron Pharmaceuticals(原名Versicor)开发,2005年9月辉瑞收购Vicuron(19亿美元),从而将本品纳入研发管线,后于2009年将dalbavancin在欧洲与北美地区用于治疗皮肤感染的开发与销售权利转让给了Durata公司。Durata公司还于2010年从RaQualia公司购得了Dalbavancin在日本用于治疗皮肤感染的开发权与销售权,但两者的协议在2015年6月中止,而RaQualia则收回了日本地区dalbavancin的相关权利。2012年,Dalbavancin用于治疗ABSSSI的适应证被FDA授予QIDP资格。2014年,Angelini收购了部分欧洲国家、俄罗斯、土耳其与独联体国家dalbavancin的销售权。2016年,Cardiome Pharma从Allergan收购了Dalbavancin在法国、英国、德国、比利时、北欧国家等欧洲国家以及中东地区与加拿大的销售权。
Allergan的相关年报数据显示,2016年Dalbavancin的全球销售额为3070万美元,同比增长128.93%。
3. Tedizolid
Tedizolid是最早由韩国Dong A开发的一种恶唑烷酮类抗菌药,本品与细菌核糖体的50S亚单位结合后抑制细菌蛋白质的合成。2007年,Trius公司从Dong A公司收购了韩国以外地区Tedizolid的研发、生产与销售权,该公司后于2013年被Cubist公司收购(7.04亿美元),而Cubist于2014年12月又被Merck 公司收购(92亿美元)。2011年,Trius公司将亚洲、非洲、拉丁美洲与中东等除了朝鲜半岛以外地区的Tedizolid用于治疗细菌性感染的相关权利转让给了Bayer公司。2013年,Tedizolid用于治疗医院获得性/呼吸机相关性细菌性肺炎(HABP/VABP)与ABSSSI的适应证获得FDA授予的QIDP资格。
Merck公司与Bayer公司均未在其年报/季报中披露tedizolid的相关销售额信息。
4. Oritavancin
Oritavancin是最早由礼来公司开发的一种脂糖肽类抗生素,具有浓度依赖性的杀菌机制。其作用机制包括:① 通过结合肽聚糖前体的干肽,从而抑制细胞壁合成中的转糖苷(聚合)步骤;② 通过结合细胞壁肽桥联成分,从而抑制细胞壁生物合成中的转肽(交联)步骤;③ 破坏细菌细菌膜的完整性,从而导致去极化、透化与细胞死亡。
Oritavancin最早由礼来公司开发,2001年,InterMune从礼来公司收购了Oritavancin的开发、生产与销售权利,但于2005年12月将相关权利转让给了Targanta。2009年,MDCO以4200多万美元的价格收购了Targanta,从而获得了Oritavancin的开发权与销售权。2013年,Oritavancin用于治疗ABSSSI的适应证获得FDA授予的QIDP资格。
5. Ceftolozane/他唑巴坦
Ceftolozane/他唑巴坦是由新型头孢菌素与β-内酰胺酶*制剂抑**所组成的复方,最早由Calixa开发,该公司于2009年12月被Cubist收购(9250亿美元)。2013年Ceftolozane/他唑巴坦用于治疗cUTI、HABP/VABP与cIAI的适应证获得FDA授予的QIDP资格。
Merck公司未在其年报/季报中披露与本品销售额相关的信息。
6. 头孢他啶/Avibactam
头孢他啶/Avibactam是由头孢菌素与新型β-内酰胺酶*制剂抑**所组成的方,其中的Avibactam最早由Novexel开发,后于2009年被转让给了Forest Laboratories,而Forest Laboratories又将头孢他啶/Avibactam用于治疗细菌感染的相关权利转让给了阿斯利康。2016年12月,阿斯利康将其包括头孢他啶/Avibactam在内的抗生素业务出售给辉瑞公司。
2013年,头孢他啶/Avibactam用于治疗cIAI、cUTI与HABP/VABP的适应证获得FDA授予的QIDP资格。
7. Delafloxacin
Delafloxacin(药用甲葡胺盐)是最早由Wakunaga Pharmaceutical公司开发的一种氟喹诺酮类抗生素,该药对MRSA与青霉素耐药性肺炎链球菌(PRSP)均具有良好的抗菌活性,其抗菌谱还包括对已有氟喹诺类药物耐药的菌株。Delafloxacin对革兰阳性菌的抗菌活性优于其他喹诺酮类,而对革兰阴性菌的抗菌活性优于或等同于环丙沙星。
2006年,Rib-X(后改名为Melinta)从Wakunaga收购了Delafloxacin所有剂型在全球范围内的开发、生产与销售权。2012年,Delafloxacin用于治疗ABSSSI与CABP的适应证被FDA授予QIDP资格。2017年3月,Melinta将美国以外68个国家与地区Delafloxacin的开放权与销售权转让给了Menarini公司。
8. 美罗培南/vaborbactam复方
美罗培南/vaborbactam是由最早由MDCO公司开发的碳青霉烯与β-内酰胺酶的复方,于2017年在美国上市用于治疗大肠杆菌、肺炎链球菌与阴沟肠杆菌所致的cUTI,相同的适应证正在接受EMA的审查。
2014年,美罗培南/vaborbactam用于治疗多药耐药性(MDR)细菌所致感染的适应证获FDA授予的QIDP资格,2016年进入快速通道。问题四、还有哪抗菌药有望在几年内上市?
由于文章篇幅与作者精力及时间的限制,本文仅对进入Ⅱ、Ⅲ期临床试验的抗MDR药物进行了检索与整理,结果如表3所示。
表3 已经进入Ⅱ、Ⅲ期临床试验阶段的抗MDR药物


总结
随着抗生素的广泛使用,细菌的耐药性问题日趋严重,而多药耐药性(MDR)细菌的出现更是给世界各国公共卫生体系构成了严峻的挑战。即使全球公认医疗条件较优越的美国,每年也会新增近200万例医院内感染患者,其中2.3万人因MDR感染死亡。此外,根据美国疾病控制与预防中心2013年的数据统计,每年因碳青霉烯耐药性肺炎克雷伯菌/大肠杆菌、MRSA、肺炎链球菌与万古霉素耐药性肠球菌(VRE)所致的死亡病例分别为600分别是600例、1.1万例、7000例与1000例。
与MDR日益严峻的发病形势形成鲜明对比的是抗菌药研发热度的持续低下,据统计,1983年~1997年间,FDA批准了40种抗生素,而1998~2011年3月,批准的数量骤降至14至。此外,1990年全球近20家大型制药在进行抗生素药物的开发,如今还能对抗生素开发保持热情的大型制药公司已经不超过5家。
为了鼓励抗生素的开发,美国奥巴马政府于2012年签署了GAIN Act,全称Generating Antibiotic Incentives Act,即《鼓励开发抗生素法案》。该法案通过QIDP资格认证、延长独占权期限与优选审查等措施,吸引更多的制药企业从事新型抗生素的研发。表2中所列的抗菌药物,除了Ceftaroline Fosamil在GAIC Act实施之前上市,其他药物均获得了FDA授予的QIDP资格认证,从而受到了GAIN Act所给予的优惠。
表2中所列的抗菌药物大多研发历程较为曲折,其相关权利几经转让,且由于大都在近三年内上市,因此无法通过公司的年报/季报等途径获取其销售额的信息。但除了Ceftaroline Fosamil以外的药物均被授予QIDP资格,这是对其临床优势的充分认可,而成功的转让也体现了各药物潜在的商业价值。
来源:医药地理